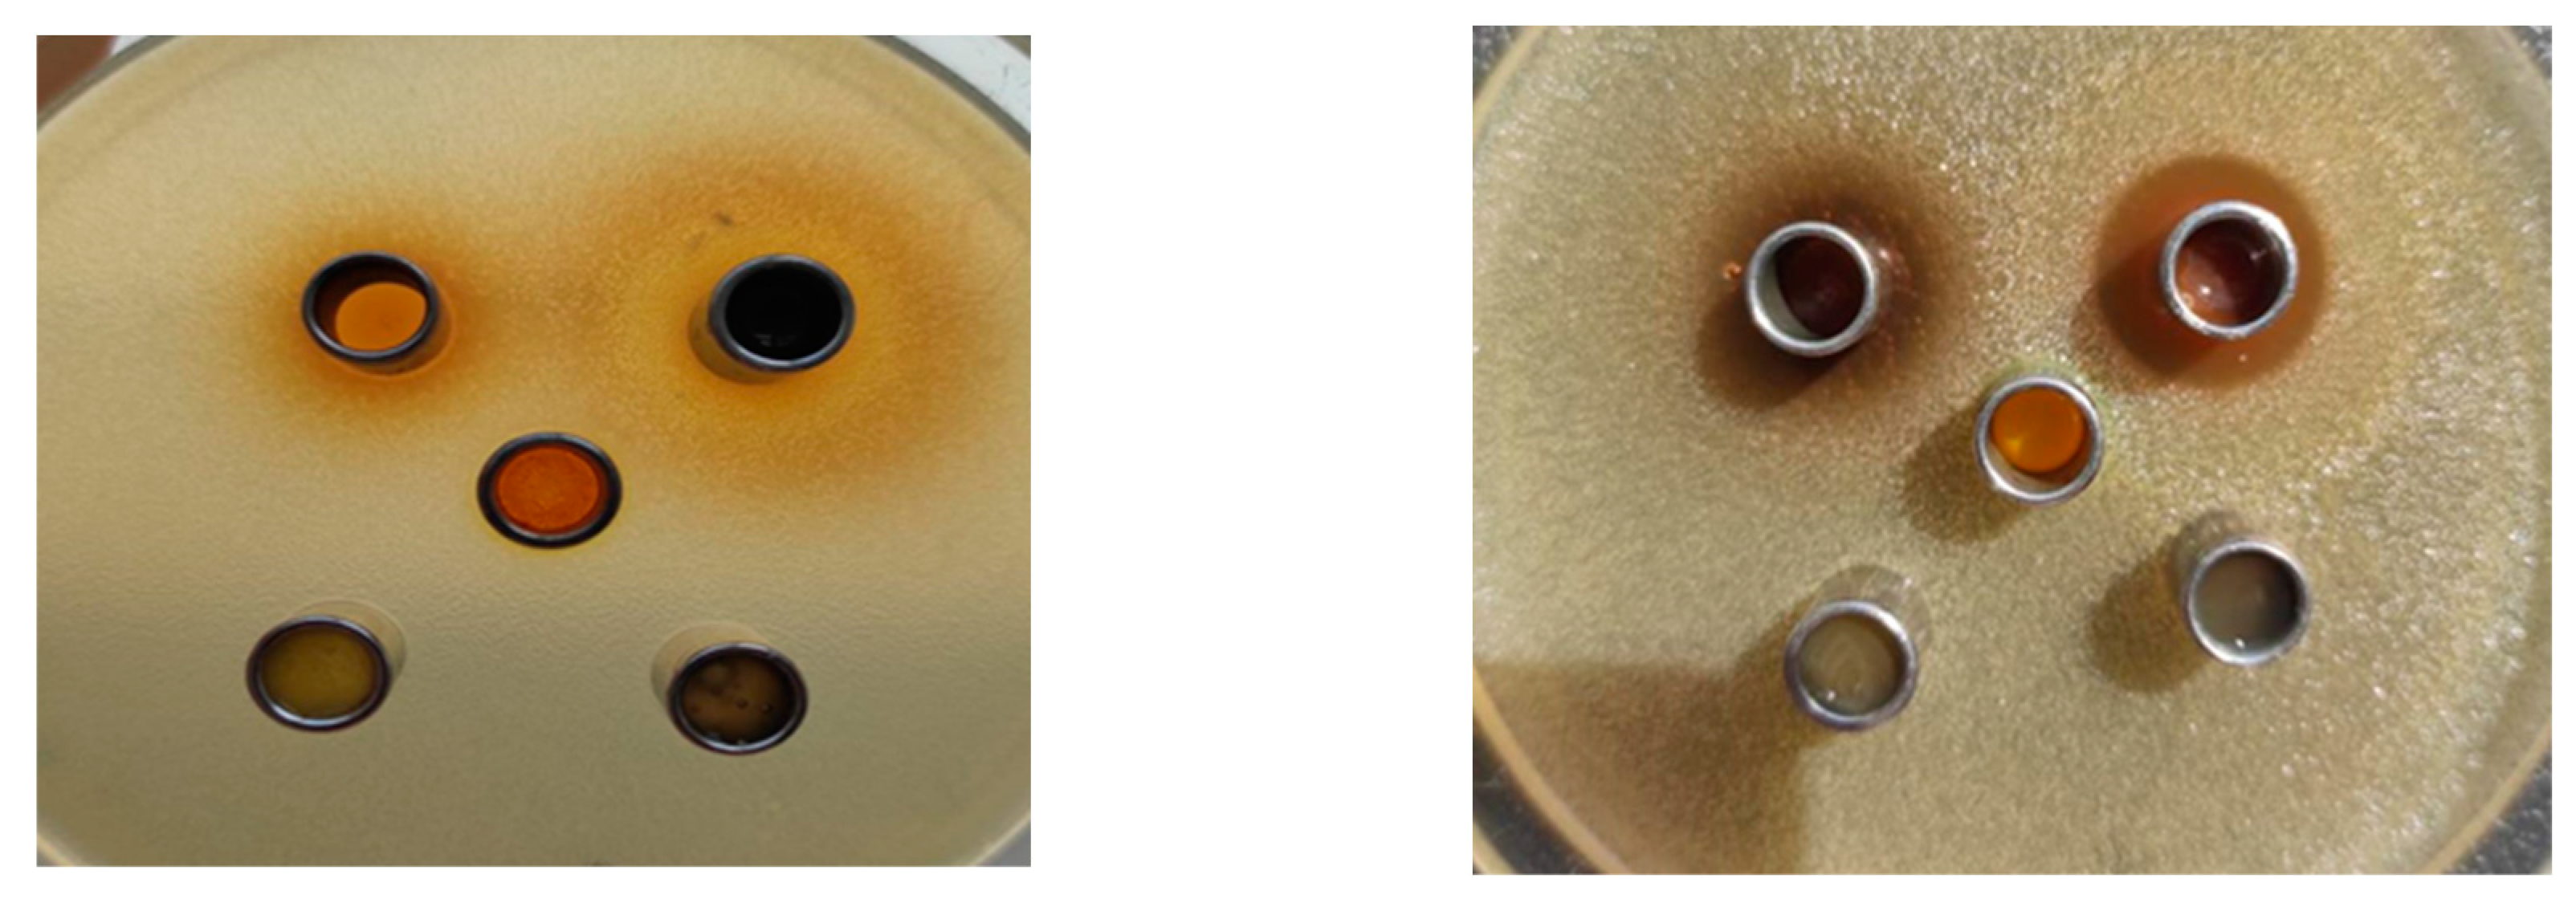

Submitted:
29 March 2024
Posted:
29 March 2024
You are already at the latest version
Abstract
Keywords:
1. Introduction
2. Materials and Methods
2.1. Materials
2.1.1. Phytochemistry
2.1.2. Flavonoids
2.1.3. Phenolic Glycosides
2.1.4. Non-Phenolic Glycosides

2.1.5. Organic Acids

2.1.6. Simple Phenolics

2.1.7. Sterols and Terpenes

2.1.8. Lignans

2.1.9. Volatiles

2.1.10. Pharmacological Activity
2.1.11. Anti-Inflammatory Activity
2.1.12. HPLC Method
2.2. Methods


3.2.1. Extraction Method for a Aqueous Extracts
3.2.2. Antimicrobial Assay
2.3. Procedure for Molecular Docking
3. Results
3.1. Experimental Antimicrobial Activity Results
3.2. Molecular Docking Studies Results
3.2.1. Results on Escherichia coli Simulations
3.2.2. Results on Staphylococcus aureus Simulations
3.2.3. Results on Candida albicans Simulations
4. Discussion
5. Conclusions
Author Contributions
Funding
Institutional Review Board Statement
Informed Consent Statement
Data Availability Statement
Acknowledgments
Conflicts of Interest
References
- Isebrands, J. G., and Richardson, J.,Poplars and willows: trees for society and the environment. Boston, USA: The Food and Agriculture Organization of the United Nations and CABI, 634, 2014.
- Thadeo, M., Azevedo A. A. and Meira, R. M. S. A., Foliar anatomy of neotropical Salicaceae: potentially useful characters for taxonomy. Plant Systemat. Evol. 300, 2073–2089. [CrossRef]
- Christenhusz M. J., M., and Byng, J. W.,The number of known plants species in the world and its annual increase,Phytotaxa261, 201–217. [CrossRef]
- Kuzovkina Y. A., and Vietto, L.,An update on the cultivar registration of Populus and Salix (Salicaceae). Skvortsovia 2014, 1, 133–148.
- Rates, S.M.K., Plants as source of drugs, Toxicon,39: 603-613. [CrossRef]
- Saller R., J. Melzer and M. Felder,Pain relief with a proprietary extract of Willow bark in rheumatology, An Open Trial. Schweiz. Zschr. GanzheitsMedizin, 20: 156-162. [CrossRef]
- Mahdi J.G., A. Mahdi J.G., A.J. Mahdi, A.J. Mahdi and I.D. Bowen,The historical analysis of aspirin discovery, its relation to the willow tree and antiproliferative and anticancer potential. Cell Prolif., 39: 147-55. [CrossRef]
- et al. ,American Journal of Biochemistry and Biotechnology 9 (1): 41-46,Science Publications 46 AJBB, 2013 https://www.frontiersin.org/articles/10.3389/fphar.2021.593856/full#supplementary-material.
- Du, Q., Jerz G., and Winterhalter P., Preparation of three flavonoids from the bark of Salix alba by high-speed countercurrent chromatographic separation. J. Liq. Chromatogr. Relat. Technol. 27, 3257–3264. [CrossRef]
- Li, W., Shi, L. L., Han, L. Q., and Zhang, J., Development and validation of a RP-HPLC method for simultaneous determination of salicin and eight flavonoids in leaves of Salix Matsudana Koidz. Acta Chromatograph. 25,735–743. [CrossRef]
- Han L. K., Sumiyoshi M., Zhang, J., Liu M. X., Zhang X. F., Zheng Y. N., et al.,Anti-obesity action of Salix matsudana leaves (Part 1). Anti-obesity action by polyphenols of Salix matsudana in high fat-diet treated rodent animals. Phytother. Res. 17, 1188–1194. [CrossRef]
- Tawfeek, N., Sobeh,M., Hamdan D. I., Farrag N., Roxo, M., El-Shazly A. M. et al., Phenolic compounds from Populus alba L. and Salix subserrata Willd.(Salicaceae) counteract oxidative stress in Caenorhabditis elegans,Molecules 24, 1999. [CrossRef]
- Fernandes, C. C., de Carvalho Cursino, L. M., Novaes, J. d. A. P., Demetrio, C. A.,Júnior, O. L. P., Nunez, C. V., et al.,Salicylates isolated from leaves and stems of Salix martiana Leyb. (Salicaceae). Quím. Nova. 32,983–986. [CrossRef]
- Zapesochnaya, G. G., Kurkin, V. A., Braslavskii, V. B., and Filatova, N. V. Phenolic compounds of Salix acutifolia bark. Chem. Nat. Compd. 38, 314–318. [CrossRef]
- Wu, Y., Dobermann D., Beale M. H., and Ward J. L., Acutifoliside, a novel benzoic acid glycoside from Salix acutifolia. Nat. Prod. Res. 30, 1731–1739. [CrossRef]
- El-Shazly A., El-Sayed, A., and Fikrey, E., Bioactive secondary metabolites.
- from Salix tetrasperma Roxb. Z. Naturforsch. C Biosci. 67, 353–359. [CrossRef]
- Shah Z. A., Hameed A., Ahmed A., Simjee S. U., Jabeen A., Ullah A., et al.,Cytotoxic and anti-inflammatory salicin glycosides from leaves of Salix acmophylla. Phytochem. Lett. 17, 107–113. [CrossRef]
- Noleto-Dias, C., Wu, Y., Bellisai, A.,Macalpine, W., Beale, M., and Ward, J.,Phenylalkanoid glycosides (Non-Salicinoids) from wood chips of Salix triandra× dasyclados hybrid willow. Molecules 24, 1152. [CrossRef]
- Evans, T. P., Clausen, T. P., Reichardt, P. B., and Chang, S.,Structurally intriguing glucosides from Alaskan littletree willow (Salix arbusculoides). J. Nat.Prod. 58, 1897–1900. [CrossRef]
- Agnolet, S., Wiese, S., Verpoorte, R., and Staerk, D.,Comprehensive analysis of commercial willow bark extracts by new technology platform: combined use of metabolomics, high-performance liquid chromatography–solid-phase extraction–nuclear magnetic resonance spectroscopy and high-resolution radical scavenging assay. J. Chromatogr. A. 1262, 130–137. [CrossRef]
- Sobeh, M., Mahmoud, M. F., Rezq, S., Alsemeh, A. E., Sabry, O. M., Mostafa, I.,et al., Salix tetrasperma roxb. Extract alleviates neuropathic pain in rats via modulation of the NF-κB/TNF-α/NOX/iNOS pathway. Antioxidants 8, 482. [CrossRef]
- Masika, P., Sultana, N., Afolayan, A., and Houghton, P.,Isolation of two antibacterial compounds from the bark of Salix capensis. South Afr. J. Bot. 71,441–443. [CrossRef]
- Zapesochnaya, G. G., Kurkin, V. A., Braslavskii, V. B., and Filatova, N. V.,Phenolic compounds of Salix acutifolia bark. Chem. Nat. Compd. 38,314–318. [CrossRef]
- Zarger, M. S. S., Khatoon, F., and Akhtar, N., Phytochemical investigation and growth inhibiting effects of Salix alba leaves against some pathogenic fungal isolates. World J. Pharm. Pharmacol. 2014, 3, 1320–1330.
- Ahmed, A., Akbar, S., and Shah, W. A.,Chemical composition and pharmacological potential of aromatic water from Salix caprea inflorescence.Chin. J. Integr. Med. 1–5. [CrossRef]
- Pohjamo, S. P., Hemming, J. E., Willför, S. M., Reunanen, M. H., and Holmbom, B.R., Phenolic extractives in Salix caprea wood and knots. Phytochemistry,63, 165–169. [CrossRef]
- Shen, T., Tian, Y.-Q., Liu, W.-X., and Zheng, S.-Z., Acyclic diterpene-γ-lactones and flavonoid from Salix cheilophila Omitted. J. Chin. Chem. Soc. 55,401–405. [CrossRef]
- Sobeh, M., Mahmoud, M. F., Rezq, S., Alsemeh, A. E., Sabry, O. M., Mostafa, I.,et al.,Salix tetrasperma roxb. Extract alleviates neuropathic pain in rats via modulation of the NF-κB/TNF-α/NOX/iNOS pathway. Antioxidants 8, 482. [CrossRef]
- Balbaa, S., Khafagy, S., Haggag, M., and Sahsah, N.,Phytochemical study of certain Salix species cultivated in Egypt. J. Pharmacol. Sci. 1979, 20, 153–164.
- Rawat, U., Semwal, S., Semwal, D., Badoni, R., and Bamola, A., A new flavonoid glycoside from salix denticulata aerial parts. Molbank. 2009, M622. [CrossRef]
- Singh, H., Raturi, R., and Badoni, P.,Isolation of secondary metabolites from the roots of salix babylonica. Mater. Sci. Eng. 225, 012094. [CrossRef]
- Hussain, H., Badawy, A., Elshazly, A., Elsayed, A., Krohn, K., Riaz, M., et al.,Chemical constituents and antimicrobial activity of Salix subserrata. Record Nat. Prod. 2011; 5.
- Du, Q., Jerz, G., Shen, L., Xiu, L., and Winterhalter, P.,Isolation and structure determination of a lignan from the bark of Salix alba. Nat. Prod. Res. 21, 451–454. [CrossRef]
- Brereton, N. J. B., Berthod, N., Lafleur, B., Pedneault, K., Pitre, F. E., and Labrecque, M.,Extractable phenolic yield variation in five cultivars of mature short rotation coppice willow from four plantations in Quebec. Ind. Crop. Prod. 97, 525–535. [CrossRef]
- Karimi, I., Hayatgheybi, H., Kamalak, A., Pooyanmehr, M., and Marandi, Y., Chemical composition and effect of an essential oil of Salix aegyptiaca L., Salicaceae, (musk willow) in hypercholesterolemic rabbit model. Rev. Bras.Farmacogn. 21, 407–414. [CrossRef]
- Highfield, E. S., and Kemper, K. J., Long wood herbal task force white willow bark (Salix alba). Available at: www.mcp.edu/herbal/default htm (Accessed July 13, 1999),1999.
- Nathan, C., and Ding, A., Nonresolving inflammation. Cell 140, 871–882. [CrossRef]
- Kishore, R. N.,Mangilal, T., Anjaneyulu, N., Abhinayani, G., and Sravya, N.,Investigation of anti-inflammatory and invitro antioxidant activities of hydroalcoholic extract of bark of Salix tetrasperma Roxb. Int. J. Pharm.Drug Anal. 2014, 2, 506–509.
- Gutiérrez, S. D., Kuri, S. A., and Martín-Herrera, D., The bioguided fractionation and pharmacological activity of an endemic Salix canariensis species. Acta Pharm. 67, 265–273. [CrossRef]
- Tunon, H., Olavsdotter, C., and Bohlin, L., Evaluation of anti-inflammatory activity of some Swedish medicinal plants. Inhibition of prostaglandin biosynthesis and PAF-induced exocytosis. J. Ethnopharmacol. 48, 61–76. [CrossRef]
- Karawya, M. S., Ammar, N. M., and Hifnawy, M. S., Phytochemical study and evaluation of the anti-inflammatory activity of some medicinal plants growing in Egypt. Med J. Islamic World Acad. Sci. 2010, 109, 1–12.
- Li, W., Shi, L. L., Han, L. Q., and Zhang, J., Development and validation of a RP-HPLC method for simultaneous determination of salicin and eight flavonoids in leaves of Salix Matsudana Koidz. Acta Chromatograph. 25,735–743. [CrossRef]
- P.K Mukherjee, S Rai, S Bhattacharya, A Wahile, B P Saha.Marker analysis of polyherbal formulation, Triphala -a wellknown Indian traditional medicine. Indian Journal of Traditional Knowledge 2008, 7, 379–383.
- R K Harwansh, K Mukherjee, S Bhadra, A Kar, S Bahadur, A Mitra, P K Mukherje. Cytochrome P450 inhibitory potential and RP-HPLC standardization of trikatu-A Rasayana from Indian Ayurveda. Journal of Ethnopharmacology 2014, 153, 674–681. [CrossRef]
- A Teruaki, Y Tetsuro, K Kyoich, H Masao. Evaluation of salicin as an antipyretic prodrug that does not cause gastric injury. Planta Med 2002, 68, 714–718. [CrossRef]
- N G Bissett. Herbal drugs and phyto-pharmaceuticals.MedPharm CRC Press, Stuttgart, 566, 1994.
- M McGuffin, C Hobbs, R Upton, A Goldberg. American Herbal Products Association’s Botanical Safety Handbook; Boca Raton. CRC Press, New York, 231, 1997.
- B Meier, D Lehmann, O Sticher, A Bettschart. Identification and determination of 8 phenol glycosides each in Salix purpurea and S. daphnoides by modern high pressure liquid chromatography. Pharmaceutica Acta Helvetiae 1985, 60, 269–275.
- S E Zaugg, D Cefalo, E B Walker. Capillary electrophoretic analysis of salicin in Salix spp. Journal of Chromatography 1997, 781, 487–490. [CrossRef]
- H Thieme. On the tannin content of willow cortex. Pharmazie 1968, 23, 212.
- Willow Bark Monograph, in European Pharmacopoeia, Volume I, pp. 1561-1562, 2017.
- Hatamleh, A.A.; Al Farraj, D.; Al-Saif, S.S.; Chidambaram, S.; Radhakrishnan, S.; Akbar, I. Synthesis, Cytotoxic Analysis, and Mo-lecular Docking Studies of Tetrazole Derivatives via N-Mannich Base Condensation as Potential Antimicrobials. Drug Des. Dev. Ther. 2020, 14, 4477–4492. [CrossRef]
- Schroder, V.; Radu, N.; Cornea, P.C.; Coman, O.A.; Pirvu, L.C.; Mohammed, M.S.O.; Stefaniu, A.; Pintilie, L.; Bostan, M.; Cara-mihai, M.D.; et al. Studies Regarding the Antimicrobial Behavior of Clotrimazole and Limonene. Antibiotics, 11, 1816. [CrossRef]
- Bellon, S.; Parsons, J.D.; Wei, Y.; Hayakawa, K.; Swenson, L.L.; Charifson, P.S.; Lippke, J.A.; Aldape, R.; Gross, C.H. Crystal structures of Escherichia coli topoisomerase IV ParE subunit (24 and 43 kilodaltons): a single residue dictates differences in novobiocin po-tency against topoisomerase IV and DNA gyrase. Agents Chemother. 2004, 48, 1856–1864. [Google Scholar] [CrossRef]
- Whitlow, M.; Howard, A.J.; Stewart, D.; Hardman, K.D.; Kuyper, L.F.; Baccanari, D.P.; Fling, M.E.; Tansik, R.L. X-ray crystallographic studies of Candida albicans dihydrofolate reductase. High resolution structures of the holoenzyme and an inhibited ternary complex. J. Biol. Chem. 1997, 272, 30289–30298. [Google Scholar] [CrossRef]
- Lipinski, C.A.; Lombardo, F.; Dominy, B.W.; Feeney, P.J. Experimental and computational aproaches to estimate solubility and permeability in drug discovery and development settings. Adv. Drug Deliv. Rev. 2001, 46, 3–26. [Google Scholar] [CrossRef]
- Islam, M. S.; Zahan, R.; Nahar, L. M.; Alam, B.; Naznin, M.; Sarka, GC.; Mosaddik, M.A.; Haque, M.E. Antibacterial, insecticidal and in vivo cytotoxicity activities of salix tetrasperma. IJPSR 2011, 2, 2103–2108. [Google Scholar]
- Pop, C.; Dan Vodnar, D. Ranga, F.; Socaciu, C. Comparative Antibacterial Activity of Different Plant Extracts in Relation to their Bioactive Molecules, as Determined by LC-MS Analysis. Bulletin UASVM Animal Science and Biotechnologies 2013, 70, 86–94.
- Ramos, P.A.B.; Moreirinha, C; Santos, S. A.O.; Almeida, A.; Freire, C. S.R.; Silva, A.M.S.; Silvestre, A. J.D. Valorisation of bark lipophilic fractions from three Portuguese Salix species: A systematic study of the chemical composition and inhibitory activity on Escherichia coli. Ind. Crops Prod., 132, 245–252. [CrossRef]
- Ramadhani, S.; Santoni, A.; Efdi, M. Antibacterial Activity and Structure Elucidation of Salicin from Stem Bark of Salix tetrasper-ma ROXB. 2019. [Google Scholar]
- Tienaho, J.; Reshamwala, D.; Sarjala, T.; Kilpeläinen, P.; Liimatainen, J.; Dou, J.; Viherä-Aarnio, A.; Linnakoski, R.; Marjomäki, V.; Jyske, T. Salix spp. Bark Hot Water Extracts Show Antiviral, Antibacterial, and Antioxidant Activities-The Bioactive Properties of 16 Clones. Front. Bioeng. Biotechnol. 2021, 9, 797939.
- Tawfeek, N.; Mahmoud, M.F.; Hamdan, D.I.; Sobeh, M.; Farrag, N.; Wink, M.; El-Shazly, A.M. Phytochemistry, Pharmacology and Medicinal Uses of Plants of the Genus Salix: An Updated Review. Front. Pharmacol. 2021, 12, 593856. [Google Scholar] [CrossRef]
- Dou, J.; Ilina, P.; Hemming, J.; Malinen, K.; Mäkkylä, H. Effect of Hybrid Type and Harvesting Season on Phytochemistry and Antibacterial Activity of Extracted Metabolites from Salix Bark. J. Agric. Food Chem. 2022, 9, 2948–2956. [Google Scholar] [CrossRef]
- Dou, J.; Ilina, P.; Cruz, CD.; Nurmi, D.; Vidarte, PZ.; Rissanen, M.; Tammela, P.; Vuorinen, T. Willow Bark-Derived Material with Antibacterial and Antibiofilm Properties for Potential Wound Dressing Applications. J. Agric. Food Chem. 2023, 71, 16554–16567. [Google Scholar] [CrossRef]
- Häsler, G.S., Sommerauer, L.; Schnabel, T.; Oostingh, G.J.; Schuster, A. Antioxidative and Antimicrobial Evaluation of Bark Ex-tracts from Common European Trees in Light of Dermal Applications. Antibiotics;12(1),130. [CrossRef]














| Ligand | Score | RMSD (Å) |
Amino acids group interaction |
Hydrogen bond |
Bond Length (Å) |
|---|---|---|---|---|---|
| NOV | -51.89 | 0.77 | ASP 1077, ARG 1132, PRO 1075, ALA 1086, MET 1074, ARG 1072, GLY 1073, THR 1163, ILE 1090, ASP 1069, GLY 1071, GLU 1046, ASN 1042, SER 1043, ASP 1045 | O sp3 (O3) – O sp2 ASP 1077 O sp3 (O3) – O sp2 ASP 1077 O sp3 (O11) – N sp2 ARG 1132 O sp3 (O11) – N sp2 ARG 1132 N sp3(N1) – O sp2 ASP 1069 O sp3 (O6) – O sp2 ASN 1042 |
3.122 2.686 3.152 3.106 2.645 2.730 |
| Salicin | -49.75 | 0.06 | LEU 1091, ILE 1090, VAL 1039, VAL 1067, ASN 1042, VAL 1165, SER 1043, SER 1164, ASP 1069, GLU 1046, THR 1163, MET 1074, GLY 1162, GLY 1071, GLY 1073, ARG 1072, PRO 1075, ARG 1132. | O sp3 (O7) – O sp3 SER 1043 O sp3 (O7) – N sp2 SER 1043 O sp3 (O7) – O sp2 ASP 1069 O sp3 (O5) – O sp2 ASP 1069 O sp3 (O5) – O sp2 ASP 1069 O sp3 (O5) – O sp3 THR 1163 O sp3 (O3) – O sp2 GLU 1046 O sp3 (O3) – N sp2 ARG 1072 O sp3 (O3) – N sp2 GLY 1073 O sp3 (O4) – O sp2 GLY 1073 |
2.678 3.200 3.100 2.824 3.286 2.656 2.660 2.950 2.780 3.044 |
| Ligand | Score | Group interaction |
Hydrogen bond |
Bond Length, (Å) |
Steric interactions | Distance (Å) |
|---|---|---|---|---|---|---|
| NOV | -100.89 |
ALA 1086, ARG 1072, ARG 1132, ASN 1042, ASP 1045, ASP 1069, ASP 1077, GLU 1046, GLY 1073, ILE 1090, MET 1074, PRO 1075, SER 1043, THR1163 | O sp3 (O1) – O sp2 ASN 1042 N sp2(N1) – O sp2 ASP 1069 O sp3 (O3) – O sp3 ASP 1077 O sp3 (O11) – N sp2 ARG 1132 O sp2 (O11) – N sp2 ARG 1132 |
2.729 2.645 2.685 3.105 3.152 |
C sp2 (C18) – N sp2 ARG 1077 C sp2 (C8) – N sp2 ARG 1072 |
3.17 3.16 |
| Salicin |
-98.29 |
ARG 1072, ARG 1132, ASN 1042, ASP 1069, GLU 1046, GLY 1071, GLY 1073, GLY 1162, ILE 1090, MET 1074, PRO 1075, SER 1043, THR 1163, VAL 1039, VAL 1067, VAL 1165 | O sp3 (O7) – O sp2 VAL 1039 O sp3 (O7) – O sp3 SER 1043 O sp3 (O5) – O sp2 ASP 1069 O sp3 (O5) – O sp3 THR 1063 O sp3 (O3) – N sp2 GLY 1073 O sp3 (O3) - N sp2 ARG 1072 O sp3 (O3) - O sp2 GLU 1046 O sp3 (O3) - O sp2 GLY 1073 |
2.735 2.818 2.835 2.601 2.743 2.942 2.617 3.082 |
C sp3 (C12) – C sp3 MET 1074 O sp3 (O5) – C sp3 THR 1163 O sp3 (O3) – C sp3 GLU 1046 O sp3 (O3) – C sp2 GLU 1046 |
3.150 2.933 3.063 2.903 |
| Ligand | Score | RMSD | Group interaction |
Hydrogen bond |
Bond Length (Å) |
|---|---|---|---|---|---|
| CPF | -80.60 | 0.67 | ASP 437, SER 1085, SER 1084, GLY 1082, GLY 459, LYS 460, ARG 458, GLU 477, DA 13:H, DC 12:H | O sp2 (O1) – O sp3 SER 1084:B O sp2 (O2) – O sp3 SER 1084:B |
2.489 2.604 |
| Salcin | -64.52 | 0.44 | ASP 437, SER 1084, GLY 459, DT 10:G, DG 9:G, DT 8:E, DG 7:E, DA 13:H, DC 12>H | O sp3 (O7) – O sp2 DT 8:E O sp3 (O7) – N sp2 DA 13:H O sp3 (O5) – O sp3 DG 9:G O sp3 (O4) – O sp3 DG 9:G O sp3 (O4) – O sp2 DC 12:H O sp3 (O3) – O sp3 DA 13:H |
2.881 3.016 2.844 3.069 3.006 3.070 |
| Ligand | Mol Dock Score | Molecule Contributions | Hydrogen bond |
Bond Length (Å) |
Electrostatic interactions / Steric interactions | Distance (Å) |
|---|---|---|---|---|---|---|
| CPF | -121.47 | ARG 458:B, ASP 512:B, ASP 1083:B, GLU 1088:B, GLY 459:B, GLY 1082:B, LYS 417:B, LYS 460:B, LYS 1043:B, SER 1084:B, ARG 1122:D, LYS 1066:D, *DA…DA:G, **DT. DA:H. | O sp2 (O1) – O sp3 SER 1084:B |
2.489 | Electrostatic interactions O sp2 (O1) – Mn O sp2 (O2) – Mn |
2.089 4.409 |
| Steric interactions O sp2 (O2) – C sp3 from SER 1084:B C sp2 (C3) – O sp3 from SER 1084:B C sp3 (C16) – C sp3 from ARG 458:B |
3.024 2.932 3.152 |
|||||
| Salicin | -94.21 | ARG 458:B, ASN 476:B, ASP 437:B, GLU 477:B, GLY 459:B, *DA…DA:G, **DT. DA:H. | O sp3 (O7) – O sp3 ASP 437:B O sp3 (O7) – O sp2 ASP 437:B O sp3 (O7) – O sp3 *DA…DA:G O sp3 (O5) – N sp2 *DA…DA:G O sp3 (O5) – O sp3 **DT. DA:H O sp3 (O3) – O sp2 ARG 458:B O sp3 (O6) – O sp2 GLU 477:B O sp3 (O6) – O sp3 **DT. DA:H O sp3 (O6) – N sp2 **DT. DA:H |
3.190 2.996 3.226 2.460 2.950 3.094 3.168 3.052 3.429 |
C sp3 (C9) – N sp2 ARG 458:B C sp3 (C13) – O sp2 GLU 477:B |
2.695 3.219 |
| Ligand | Score | RMSD (Å) |
Group interaction | Hydrogen Bond | Bond Length (Å) |
|---|---|---|---|---|---|
| Co-crystallized NDP |
-79.35 | 2.86 | LEU 121, GLU 120, SER 95, TYR 118, GLU 116, ILE 117, SER 94, ARG 79, ILE 9, ALA 93, VAL 10, SER 78, LEU 77, ILE 112, GLY 113, MET 54, ALA 11, GLY 114, ILE 19, THR 147, GLY 20, TYR 21, PHE 36, ARG 56, LYS 57, THR 58, MET 25, GLY 23, PRO 26, LYS 24 | N sp2 (N7N) – O sp2 ILE 112 O sp3 (O2D) – O sp2 ILE 19 O sp3 (O4D) – N sp2 ALA 115 O sp3 (O5D) – N sp2 ALA 115 O sp2 (O2N) – O sp3 THR 58 O sp2 (O2N – N sp2 THR 58 O sp2 (O2A) – N sp2 ALA 115 O sp2 (O2A) – N sp2 GLU 116 O sp3 (O3B) – O sp2 GLU 116 O sp3 (O3B) – N sp3 LYS 57 O sp2 (O2X) – N sp3 LYS 57 O sp2 (O2X) – N sp2 ARG 56 O sp2 (O1X) – N sp2 ARG 79 O sp2 (O3X) – N sp2 ARG 79 O sp2 (O3X) – N sp2 ARG 79 N sp2 (N3A) – N sp2 SER 78 |
3.069 2.649 3.335 3.394 2.977 3.194 3.111 2.733 2.892 2.924 2.772 2.365 2.698 2,984 3.061 3.286 |
| Salicin | -57.52 | 0.26 | SER 89, ARG 79, GLU 120, LEU 121, ILE 96, GLU 116, SER 95, SER 94, SER 78, SER 80, LEU 77, GLY 55, ALA 93, ARG 56, LYS 57, THR 58, MET 54 | O sp3 (O7) - O sp3 GLU 116 O sp3 (O7) – N sp2 ARG 79 O sp3 (O7) – N sp2 ARG 79 O sp3 (O5) – N sp2 ARG 79 O sp3 (O5) – N sp2 ARG 79 O sp3 (O3) – N sp2 ARG 56 O sp3 (O4) – N sp2 ARG 56 O sp3 (O4) – N sp3 LYS 57 O sp3 (O4) – N sp2 LYS 57 O sp3 (O6) – N sp2 LYS 57 O sp3 (O6) – N sp2 ARG 56 O sp3 (O2) – N sp2 ARG 79 O sp3 (O2) – N sp2 ARG 79 O sp3 (O2) – N sp2 ARG 79 |
3.096 3.157 3.045 2.642 2.727 2.608 3.246 3.295 3.123 2.875 3.116 3.174 3.066 3.145 |
| Ligand | Mol Dock Score | Molecule contributions | Hydrogen bond |
Bond Length (Å) |
Electrostatic interactions / Steric interactions | Distance (Å) |
|---|---|---|---|---|---|---|
| Co-crystallized NDP | -155.24 | ALA 11, ALA 12, ALA 93, ALA 115, ARG 49, ARG 56, ARG 67, ARG 72, ARG 79, ARG 191, ASP 87, ASP 146, GLU 32, GLU 60, GLU 82, GLU 84, GLU 97, GLU 116, GLU 120, GLY 20, GLY 23, GLY 55, GLY 113, GLY 114, HIS 92, ILE 19, ILE 112, ILE 117, LEU 77, LEU 121, LYS 3, LYS 14, LYS 22, LYS 24, LYS 31, LYS 37, LYS 45, LYS 57, LYS 65, LYS 150, LYS 158, LYS 178, LYS 192, MET 25, SER 78, SER 80, SER 94, SER 95, THR 58, THR 147, TRP 27, TYR 21, TYR 118, VAL 10 | N sp2 (N7N) – O sp2 ILE 19 N sp2 (N7N) – O sp2 ALA 11 O sp3 (O7N) – N sp2 ALA 11 O sp3 (O7N) – N sp2 ALA 11 O sp3 (O4D) – N sp2 ALA 115 O sp3 (O5D) – N sp2 ALA 115 O sp2 (O2A) – N sp2 GLY 114 O sp2 (O2A) – O sp3 THR 58 O sp2 (O2A) – N sp2 THR 58 O sp2 (O2N) – N sp2 GLU 116 O sp2 (O1A) – N sp2 GLU 116 O sp2 (O1A) – N sp2 ILE 117 O sp3 (O3B) – N sp3 LYS 57 O sp2 (O2X) – N sp2 ARG 56 O sp2 (O1X) – N sp2 ARG 56 O sp2 (O1X) – O sp3 SER 78 O sp2 (O3X) – N sp2 ARG 79 O sp2 (O3X) – N sp2 ARG 79 |
3.204 2.887 3.093 3.514 3.437 2.930 2.813 2.565 3.218 3.109 3.405 3.302 2.585 3.199 2.893 2.455 2.757 2.545 |
Electrostatic interactions O sp2 (O2X) – N sp2 ARG 79 O sp2 (O2X) – N sp2 ARG 56 O sp3 (O2X) – N sp3 LYS 57 O sp2 (O1X) – N sp2 ARG 79 O sp2 (O1X) – N sp2 ARG 79 O sp2 (O3X) – N sp2 ARG 56 |
3.716 3.199 4.399 2.545 4.247 3.681 |
| Steric interactions O sp2 (O1A) – N sp2 GLY 114 O sp2 (O2A) – C sp3 GLY 114 O sp2 (O1X) – C sp3 SER 78 |
3.109 3.181 3.153 |
|||||
| Salicin | - 94.82 | ARG 56, ARG 79, GLU 116, GLU 120, GLY 55, ILE 117, LEU 77, LEU 121, LYS 57, SER 78, SER 94, SER 95 | O sp3 (O7) - O sp3 GLU 116 O sp3 (O7) – N sp2 ARG 79 O sp3 (O7) – N sp2 ARG 79 O sp3 (O5) – N sp2 ARG 79 O sp3 (O5) – N sp2 ARG 79 O sp3 (O3) – N sp2 ARG 56 O sp3 (O4) – N sp2 ARG 56 O sp3 (O4) – N sp2 LYS 57 O sp3 (O4) – O sp2 GLU 116 |
2.810 3.000 3.052 2.961 2.909 3.318 2.855 2.798 3.110 |
O sp3 (O4) – C sp3 LYS 57 | 2.939 |
| Compounds | Atoms | Weight [Daltons] |
Flexible bonds |
Lipinski violations | Hydrogen donors |
Hydrogen acceptors | Log P |
|---|---|---|---|---|---|---|---|
| Salicin | 38 | 286.28 | 4 | 0 | 5 | 7 | 1.68 |
Disclaimer/Publisher’s Note: The statements, opinions and data contained in all publications are solely those of the individual author(s) and contributor(s) and not of MDPI and/or the editor(s). MDPI and/or the editor(s) disclaim responsibility for any injury to people or property resulting from any ideas, methods, instructions or products referred to in the content. |
© 2024 by the authors. Licensee MDPI, Basel, Switzerland. This article is an open access article distributed under the terms and conditions of the Creative Commons Attribution (CC BY) license (http://creativecommons.org/licenses/by/4.0/).
